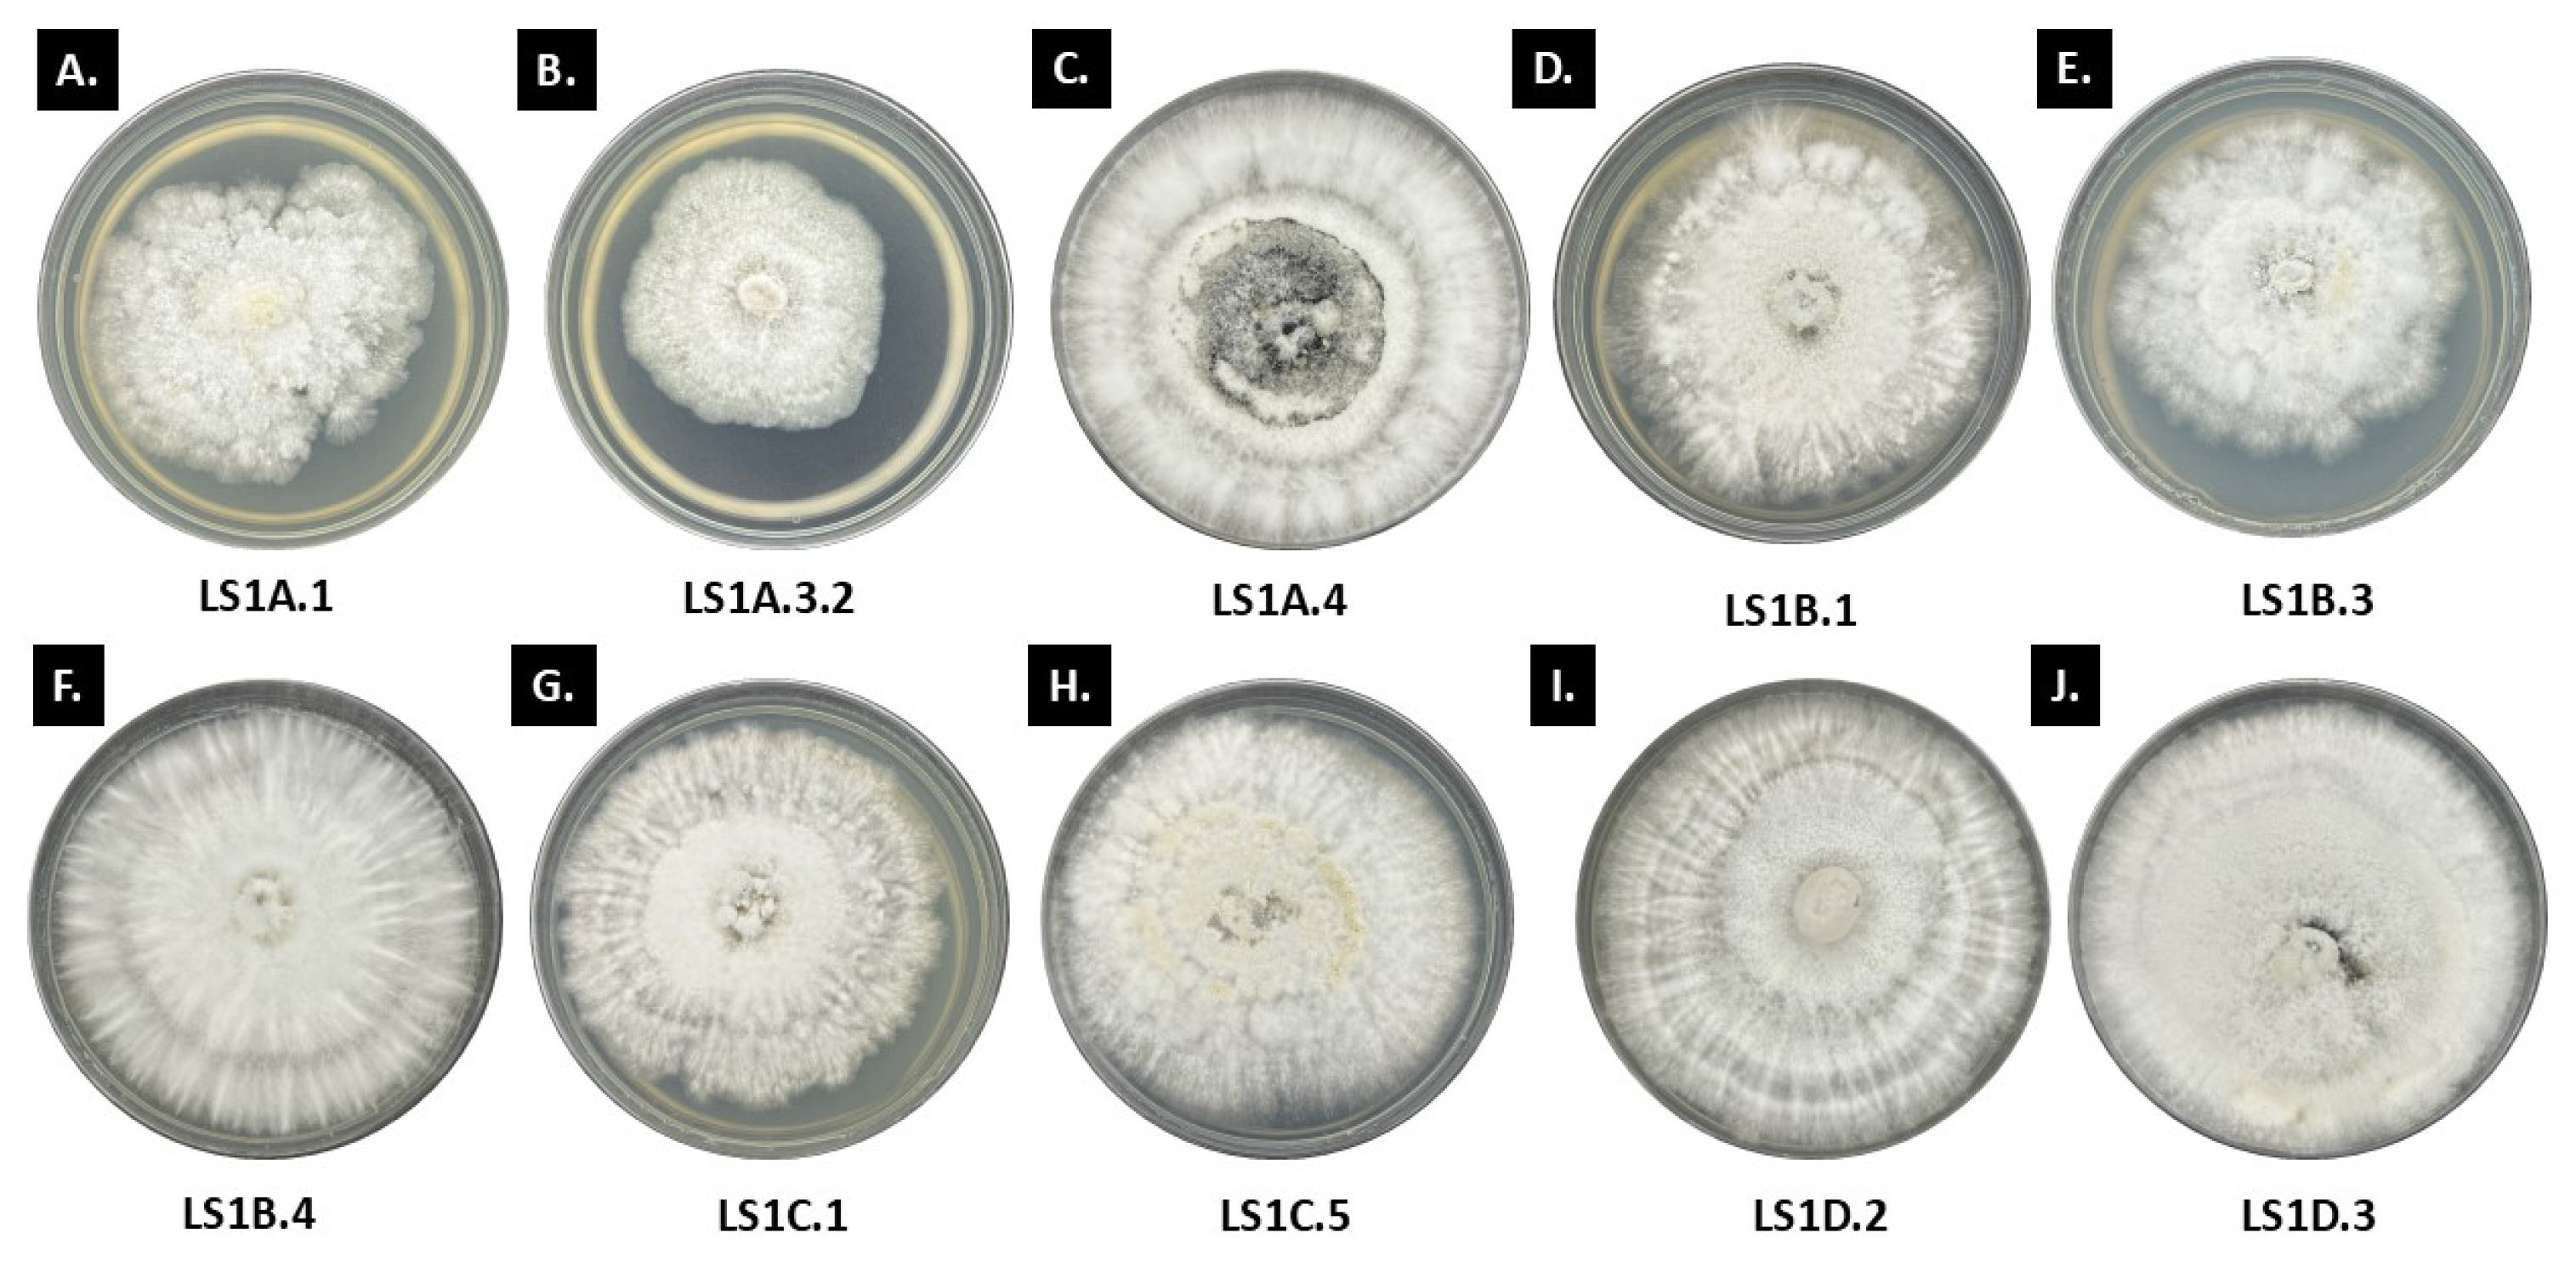
Jof 11 00302 g002a
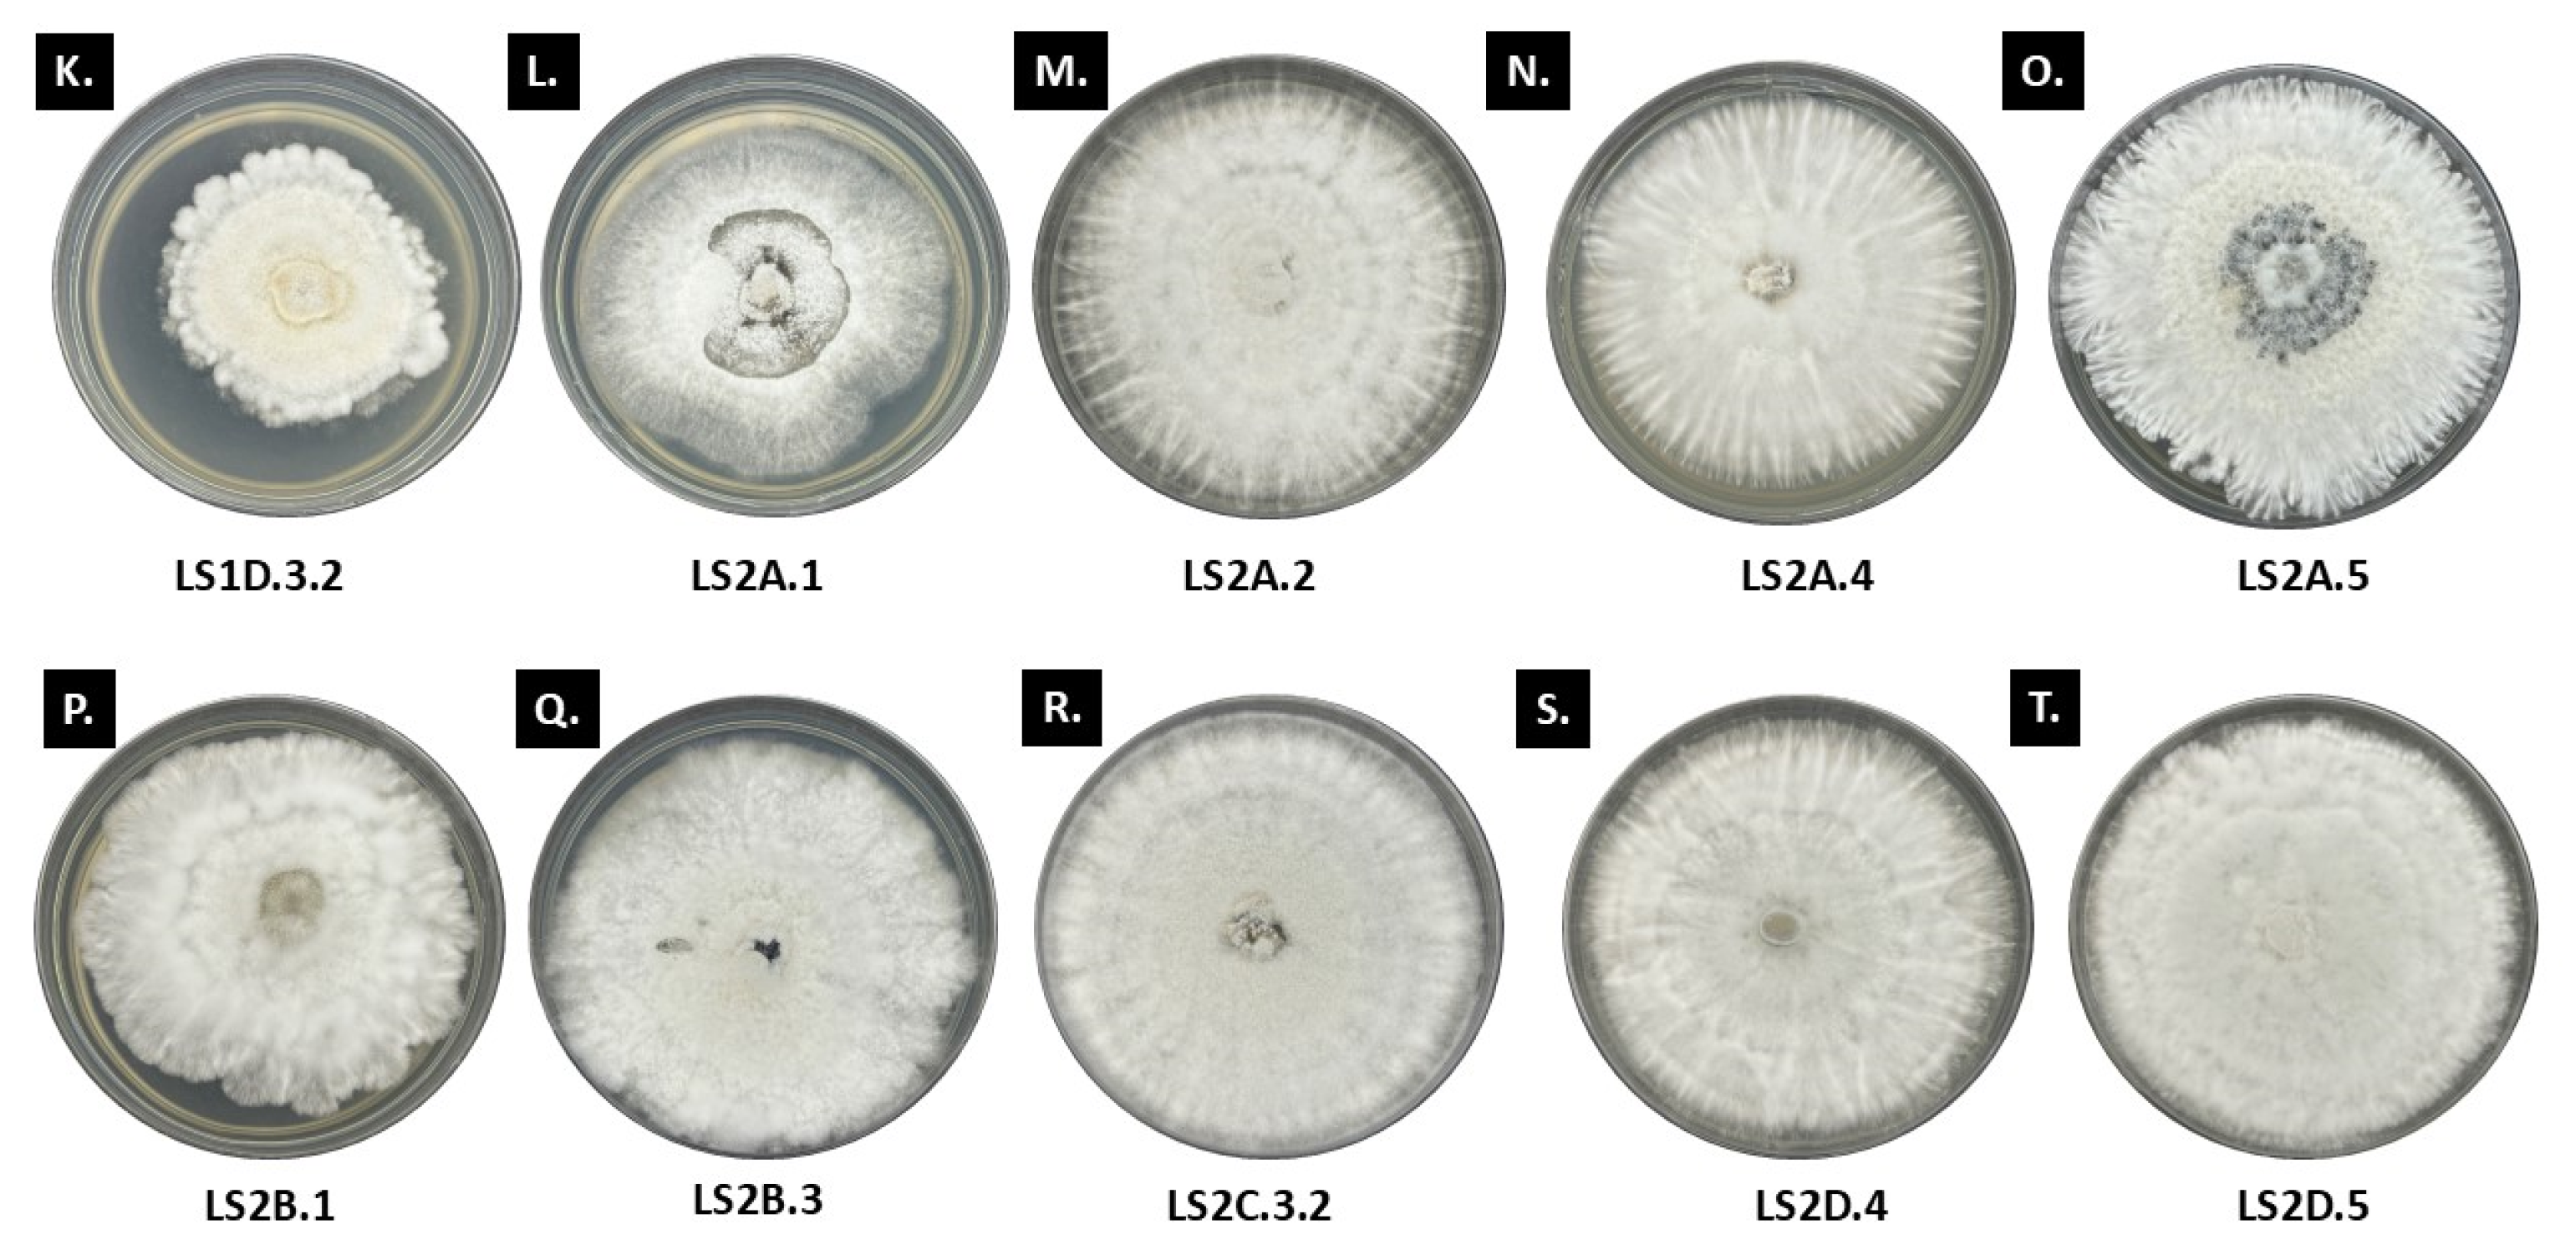
Jof 11 00302 g002b

Comparative Antagonistic Activities of Endolichenic Fungi Isolated from the Fruticose Lichens Ramalina and Usnea
Abstract
1. Introduction
2. Materials and Methods
2.1. Sampling Sites and Lichen Collection
2.2. Endolichenic Fungi Isolation and Purification
2.3. Morpho-Cultural Characterization of Endolichenic Fungi
2.4. Co-Cultivation Assay Between Endolichenic Fungi and Fungal Phytopathogens
2.5. Molecular Identification and Phylogenetic Analysis
2.6. SEM Analysis of Mycelial Interaction
2.7. Mycelial Growth Inhibition Assay
3. Results
3.1. Morpho-Cultural Traits of Ramalina and Usnea Endolichenic Fungi
3.2. Interactions Between Endolichenic Fungi and Test Fungal Phytopathogens
3.2.1. Antagonistic Activity of Ramalina ELF Isolates
3.2.2. Antagonistic Activity of Usnea ELF Isolates
3.3. Molecular Identification and Phylogenetic Analysis of Selected Endolichenic Fungi
3.4. SEM Observations
3.5. Inhibition of Mycelial Growth by Selected Endolichenic Fungi
4. Discussion
5. Conclusions
Supplementary Materials
Author Contributions
Funding
Institutional Review Board Statement
Informed Consent Statement
Data Availability Statement
Acknowledgments
Conflicts of Interest
References
- Mwangi, R.W.; Mustafa, M.; Charles, K.; Wagara, I.W.; Kappel, N. Selected emerging and reemerging plant pathogens affecting the food basket: A threat to food security. J. Agric. Food Res. 2023, 14, 100827. [Google Scholar] [CrossRef]
- Magdama, F.; Monserrate-Maggi, L.; Serrano, L.; García Onofre, J.; Jiménez-Gasco, M.D.M. Genetic Diversity of Fusarium oxysporum f. sp. cubense, the Fusarium Wilt Pathogen of Banana, in Ecuador. Plants 2020, 9, 1133. [Google Scholar]
- Bhar, A.; Jain, A.; Das, S. Soil pathogen, Fusarium oxysporum induced wilt disease in chickpea: A review on its dynamicity and possible control strategies. Proc. Indian Natl. Sci. 2021, 87, 260–274. [Google Scholar] [CrossRef]
- Achari, S.R.; Mann, R.C.; Sharma, M.; Edwards, J. Diagnosis of Fusarium oxysporum f. sp. ciceris causing Fusarium wilt of chickpea using loop-mediated isothermal amplification (LAMP) and conventional end-point PCR. Sci. Rep. 2023, 13, 2640. [Google Scholar]
- Prasath, D.; Matthews, A.; O’Neill, W.T.; Aitken, E.A.; Chen, A. Fusarium yellows of ginger (Zingiber officinale Roscoe) caused by Fusarium oxysporum f. sp. zingiberi is associated with cultivar-specific expression of defense-responsive genes. Pathogens 2023, 12, 141. [Google Scholar]
- Rizzo, D.M.; Lichtveld, M.; Mazet, J.A.; Togami, E.; Miller, S.A. Plant health and its effects on food safety and security in a One Health framework: Four case studies. One Health Outlook 2021, 3, 6. [Google Scholar] [CrossRef] [PubMed]
- Lamichhane, J.R.; You, M.P.; Laudinot, V.; Barbetti, M.J.; Aubertot, J.N. Revisiting sustainability of fungicide seed treatments for field crops. Plant Dis. 2020, 104, 610–623. [Google Scholar] [CrossRef] [PubMed]
- Kenarova, A.; Boteva, S. Fungicides in agriculture and their side effects on soil enzyme activities: A review. Bulg. J. Agric. Sci. 2023, 29, 33–42. [Google Scholar]
- Wong, H.L.; Garthwaite, D.G.; Ramwell, C.T.; Brown, C.D. How does exposure to pesticides vary in space and time for residents living near treated orchards? Environ. Sci. Pollut. Res. 2017, 24, 26444–26461. [Google Scholar] [CrossRef]
- Yadav, I.C.; Devi, N.L. Pesticides classification and its impact on human and environment. Environ. Eng. Sci. 2017, 6, 140–158. [Google Scholar]
- Sandanayake, S.; Hettithanthri, O.; Buddhinie, P.K.C.; Vithanage, M. Plant uptake of pesticide residues from agricultural soils. In Pesticides in Soils: Occurrence, Fate, Control and Remediation; Springer International Publishing: Cham, Switzerland, 2022; pp. 197–223. [Google Scholar]
- Hollomon, D.W. Fungicide resistance: 40 years on and still a major problem. In Fungicide Resistance in Plant Pathogens: Principles and a Guide to Practical Management; Springer: Tokyo, Japan, 2015; pp. 3–11. [Google Scholar]
- Wang, S.Y.; Jiang, Y.H.; Chen, X.; Herrera-Balandrano, D.D.; Simoes, M.F.; Shi, X.C.; Laborda, P. Biocontrol strategies for the management of Sclerotinia sclerotiorum in Brassica species: A review. Physiol. Mol. Plant Pathol. 2024, 130, 102239. [Google Scholar] [CrossRef]
- Gao, H.; Zou, J.; Li, J.; Zhao, H. Endolichenic fungi: A potential treasure trove for discovery of special structures and bioactive compounds. Stud. Nat. Prod. Chem. 2016, 48, 347–397. [Google Scholar]
- Spribille, T.; Fryday, A.M.; Hampton-Miller, C.J.; Ahti, T.; Dillman, K.; Thor, G.; Tonsberg, T.; Schirokauer, D. Compendium of the Lichens and Associated Fungi of Alaska; Schweizerbart: Stuttgart, Germany, 2023. [Google Scholar]
- U’Ren, J.M.; Lutzoni, F.; Miadlikowska, J.; Arnold, A.E. Community analysis reveals close affinities between endophytic and endolichenic fungi in mosses and lichens. Microb. Ecol. 2010, 60, 340–353. [Google Scholar] [CrossRef]
- Kannangara, B.T.S.D.P.; Rajapaksha, R.S.C.G.; Paranagama, P.A. Nature and bioactivities of endolichenic fungi in Pseudocyphellaria sp., Parmotrema sp. and Usnea sp. at Hakgala montane forest in Sri Lanka. Lett. Appl. Microbiol. 2009, 48, 203–209. [Google Scholar] [CrossRef] [PubMed]
- Singh, G.; Dal Grande, F.; Divakar, P.K.; Otte, J.; Crespo, A.; Schmitt, I. Fungal–algal association patterns in lichen symbiosis linked to macroclimate. New Phytol. 2017, 214, 317–329. [Google Scholar] [CrossRef]
- Santiago, K.A.A.; Edrada-Ebel, R.; dela Cruz, T.E.E.; Cheow, Y.L.; Ting, A.S.Y. Biodiscovery of potential antibacterial diagnostic metabolites from the endolichenic fungus Xylaria venustula using LC–MS-Based metabolomics. Biology 2021, 10, 191. [Google Scholar] [CrossRef]
- Wethalawe, A.N.; Alwis, Y.V.; Udukala, D.N.; Paranagama, P.A. Antimicrobial compounds isolated from endolichenic fungi: A review. Molecules 2021, 26, 3901. [Google Scholar] [CrossRef]
- Padhi, S.; Masi, M.; Panda, S.K.; Luyten, W.; Cimmino, A.; Tayung, K.; Evidente, A. Antimicrobial secondary metabolites of an endolichenic Aspergillus niger isolated from lichen thallus of Parmotrema ravum. Nat. Prod. Res. 2019, 34, 2573–2580. [Google Scholar] [CrossRef]
- Yuan, W.H.; Teng, M.T.; Yun, Y.F.; Jiang, N.; Ma, L.; Sun, S.S.; Yuan, B.; Tang, J.; Wu, Q.Y.; Li, Q.; et al. Talarolactone A, an isocoumarin derivative fused with dihydrothiophene with selective antimigratory activity from the endolichenic fungus Talaromyces sp. J. Nat. Prod. 2020, 83, 1716–1720. [Google Scholar] [CrossRef]
- Xu, K.; Li, R.; Zhu, R.; Li, X.; Xu, Y.; He, Q.; Xie, F.; Qiao, Y.; Luan, X.; Lou, H. Xylarins A–D, two pairs of diastereoisomeric isoindoline alkaloids from the endolichenic fungus Xylaria sp. Org. Lett. 2021, 23, 7751–7754. [Google Scholar] [CrossRef]
- Aursnes, M.; Primdahl, K.G.; Liwara, D.; Solum, E.J. A modular strategy for the synthesis of dothideopyrones E and F, secondary metabolites from an endolichenic fungus. J. Nat. Prod. 2023, 86, 804–811. [Google Scholar] [CrossRef] [PubMed]
- Kim, S.K.; Dickinson, M.S.; Finer-Moore, J.; Guan, Z.; Kaake, R.M.; Echeverria, I.; Chen, J.; Pulido, E.H.; Sali, A.; Krogan, N.J.; et al. Structure and dynamics of the essential endogenous mycobacterial polyketide synthase Pks13. Nat. Struct. Mol. Biol. 2023, 30, 296–308. [Google Scholar] [CrossRef]
- Zhai, Y.J.; Zhou, Z.Z.; Gao, L.L.; Li, J.N.; Pescitelli, G.; Gao, J.M.; Han, W.B. Ethylidene-Tethered Chromene–Pyrone Hybrids as Potential Plant-Growth Regulators from an Endolichenic Phaeosphaeria Species. J. Agric. Food Chem. 2023, 71, 4615–4624. [Google Scholar] [CrossRef]
- Xie, F.; Luan, X.Y.; Gao, Y.; Xu, K.; Lou, H.X. Cytotoxic heptaketides from the endolichenic fungus Ulospora bilgramii. J. Nat. Prod. 2020, 83, 1623–1633. [Google Scholar] [CrossRef]
- Yuan, W.H.; Teng, M.T.; Sun, S.S.; Ma, L.; Yuan, B.; Ren, Q.; Zhang, P. Active metabolites from endolichenic fungus Talaromyces sp. Chem. Biodivers. 2018, 15, e1800371. [Google Scholar] [CrossRef]
- Miral, A.; Ferron, S.; Rouaud, I.; Slyambayev, D.; Bousarghin, L.; Camuzet, C.; Belouzard, S.; Séron, K.; Le Pogam, P.; Tranchimand, S.; et al. Eremoxylarins D–J, Antibacterial Eremophilane Sesquiterpenes Discovered from an Endolichenic Strain of Xylaria hypoxylon. J. Nat. Prod. 2023, 86, 730–738. [Google Scholar] [CrossRef] [PubMed]
- Basnet, B.B.; Chen, B.; Suleimen, Y.M.; Ma, K.; Guo, S.; Bao, L.; Huang, Y.; Liu, H. Cytotoxic secondary metabolites from the endolichenic fungus Hypoxylon fuscum. Planta Med. 2019, 85, 1088–1097. [Google Scholar] [CrossRef] [PubMed]
- Tan, M.; Castro, S.; Oliva, P.M.; Yap, R.P.; Nakayama, A.; Magpantay, H.; dela Cruz, T.E.E. Biodiscovery of antibacterial constituents from the endolichenic fungi isolated from Parmotrema rampoddense. 3Biotech 2020, 10, 212. [Google Scholar] [CrossRef]
- Lin, L.B.; Gao, Y.Q.; Han, R.; Xiao, J.; Wang, Y.M.; Zhang, Q.; Zhai, Y.J.; Han, W.B.; Li, W.L.; Gao, J.M. Alkylated salicylaldehydes and prenylated indole alkaloids from the endolichenic fungus Aspergillus chevalieri and their bioactivities. J. Agric. Food Chem. 2021, 69, 6524–6534. [Google Scholar] [CrossRef]
- Santiago, K.A.A.; dela Cruz, T.E.E.; Ting, A.S.Y. Endolichenic fungi from common Usnea lichens found in a montane forest in Malaysia: A study on diversity and bioactivity profiling. Asian J. Mycol. 2022, 5, 18–37. [Google Scholar] [CrossRef]
- Li, W.; Gao, W.; Zhang, M.; Li, Y.L.; Li, L.; Li, X.B.; Chang, W.Q.; Zhao, Z.T.; Lou, H.X. p-Terphenyl derivatives from the endolichenic fungus Floricola striata. J. Nat. Prod. 2016, 79, 2188–2194. [Google Scholar] [CrossRef] [PubMed]
- Chen, S.C.; Ren, J.J.; Zhao, H.J.; Wang, X.L.; Wang, T.H.; Jin, S.D.; Wang, Z.H.; Li, C.Y.; Liu, A.R.; Lin, X.M.; et al. Trichoderma harzianum improves defense against Fusarium oxysporum by regulating ROS and RNS metabolism, redox balance, and energy flow in cucumber roots. Phytopathology 2019, 109, 972–982. [Google Scholar] [CrossRef]
- Song, J.; Xie, F.; Luan, X.; Xu, K.; Qian, L.; Lu, J.; Chang, W.; Wang, X.; Lou, H. Perylenequinone derivatives from the endolichenic fungus Phialocephala fortinii. Nat. Prod. Res. 2023, 37, 1527–1535. [Google Scholar] [CrossRef] [PubMed]
- Gamage, C.D.; Lee, K.; Park, S.Y.; Varlı, M.; Lee, C.W.; Kim, S.M.; Zhou, R.; Pulat, S.; Yang, Y.; Tas, I.; et al. Phthalides isolated from the endolichenic Arthrinium sp. EL000127 exhibits antiangiogenic activity. ACS Omega 2023, 8, 12548–12557. [Google Scholar] [CrossRef] [PubMed]
- Galinato, M.G.M.; Bungihan, M.E.; Santiago, K.A.A.; Sangvichien, E.; dela Cruz, T.E.E. Antioxidant activities of fungi inhabiting Ramalina peruviana: Insights on the role of endolichenic fungi in the lichen symbiosis. Curr. Res. Environm. Appl. Mycol. 2021, 11, 119–136. [Google Scholar] [CrossRef]
- Kawakami, H.; Watabe, N.; Matsubuchi, Y.; Hara, K.; Komine, M. Antioxidant compounds produced by endolichenic fungus Penicillium sp. strain 1322P isolated from Pyxine subcinerea. Arch. Microbiol. 2024, 206, 187. [Google Scholar] [CrossRef]
- Xu, K.; Li, G.; Zhu, R.; Xie, F.; Li, Y.; Yang, W.; Xu, L.; Shen, T.; Zhao, Z.; Lou, H. Polyketides from the endolichenic fungus Eupenicillium javanicum and their anti-inflammatory activities. Phytochemistry 2020, 170, 112191. [Google Scholar] [CrossRef]
- Zhai, Y.J.; Li, J.N.; Gao, Y.Q.; Gao, L.L.; Wang, D.C.; Han, W.B.; Gao, J.M. Structurally diverse sesquiterpenoids with anti-neuroinflammatory activity from the endolichenic fungus Cryptomarasmius aucubae. Nat. Prod. Bioprospect. 2021, 11, 325–332. [Google Scholar] [CrossRef]
- Petrini, O.; Hake, U.; Dreyfuss, M.M. An analysis of fungal communities isolated from fruticose lichens. Mycologia 1990, 82, 444–451. [Google Scholar] [CrossRef]
- Girlanda, M.; Isocrono, D.; Bianco, C.; Luppi-Mosca, A.M. Two foliose lichens as microfungal ecological niches. Mycologia 1997, 89, 531–536. [Google Scholar] [CrossRef]
- dela Cruz, T.E.E.; Santiago, K.A.A. In pursuit of promising microbes for drug discovery: Tapping endolichenic fungi (ELF) from lichens. Acta Manil. 2021, 69, 53–66. [Google Scholar] [CrossRef]
- Ting, A.S.Y.; Cheng, C.K.W.; Santiago, K.A.A. Decolourization of malachite green dye by endolichenic fungi from the lichen Usnea sp.: A novel study on their dye removal potential. J. King Saud Univ.-Sci. 2021, 33, 101579. [Google Scholar] [CrossRef]
- Dumo, E.D.; Espino, A.J.; Lina, F.D.; Pua, K.D.; Paguirigan, J.A. Antibacterial potential of endolichenic fungi from lichen Usnea. Asian J. Mycol. 2023, 6, 51–57. [Google Scholar]
- Bajpai, R.; Yusuf, M.A.; Upreti, D.K.; Gupta, V.K.; Singh, B.N. Endolichenic fungus, Aspergillus quandricinctus of Usnea longissima inhibits quorum sensing and biofilm formation of Pseudomonas aeruginosa PAO1. Microb. Pathog. 2020, 140, 103933. [Google Scholar]
- dela Cruz, T.E.E.; Paguirigan, J.A.G.; Santiago, K.A.A. Lichens in the Philippines: Diversity and applications in natural product research. In Mycology in the Tropics; Academic Press: Cambridge, MA, USA, 2023; pp. 147–160. [Google Scholar]
- Kumari, A.; Joshi, H.; Tripathi, A.H.; Chand, G.; Joshi, P.; Tewari, L.M.; Joshi, Y.; Upreti, D.K.; Bajpai, R.; Upadhyay, S.K. Assessment of In-Vitro Culture as a Sustainable and Eco-friendly Approach of Propagating Lichens and Their Constituent Organisms for Bioprospecting Applications. Biotechnol. Environ. Remediat. 2023, 129–154. [Google Scholar] [CrossRef]
- Santiago, K.A.; Borricano, J.N.; Canal, J.; Marcelo, D.M.; Perez, M.C.; dela Cruz, T.E.E. Antimicrobial activities of selected fruticose lichens from different sites in Luzon. Philipp. Sci. Lett. 2010, 3, 18–29. [Google Scholar]
- Gazo, S.M.T.; Santiago, K.A.A.; Tjitrosoedirjo, S.S.; dela Cruz, T.E.E. Antimicrobial and herbicidal activities of the fruticose lichen Ramalina from Guimaras Island, Philippines. Biotropia 2019, 26, 23–32. [Google Scholar] [CrossRef]
- Paranagama, P.A.; Wijeratne, E.K.; Burns, A.M.; Marron, M.T.; Gunatilaka, M.K.; Arnold, A.E.; Gunatilaka, A.L. Heptaketides from Corynespora sp. inhabiting the cavern beard lichen, Usnea cavernosa: First report of metabolites of an endolichenic fungus. J. Nat. Prod. 2007, 70, 1700–1705. [Google Scholar] [CrossRef]
- Asthana, A.; Shearer, C.A. Antagonistic activity of Pseudohalonectria and Ophioceras. Mycologia 1990, 82, 554–561. [Google Scholar] [CrossRef]
- Pecundo, M.H.; dela Cruz, T.E.E.; Chen, T.; Notarte, K.I.; Ren, H.; Li, N. Diversity, phylogeny and antagonistic activity of fungal endophytes associated with endemic species of Cycas (Cycadales) in China. JoF 2021, 7, 572. [Google Scholar] [CrossRef]
- Wicklow, D.T.; Hesseltine, C.W.; Shotwell, O.L.; Adams, G.L. Interference competition and aflatoxin levels in corn. Phytopathology 1981, 70, 761–764. [Google Scholar] [CrossRef]
- White, T.J.; Bruns, T.D.; Lee, S.; Taylor, J.W. Amplification and Direct Sequencing of Fungal Ribosomal RNA Genes for Phylogenetics. In PCR Protocols: A Guide to Methods and Applications; Innis, M.A., Gelfand, D.H., Sninsky, J.S., White, T.J., Eds.; Academic Press: San Diego, CA, USA, 1990; pp. 315–322. [Google Scholar]
- Katoh, K.; Standley, D.M. MAFFT multiple sequence alignment software version 7: Improvements in performance and usability. Mol. Biol. Evol. 2013, 30, 772–780. [Google Scholar] [CrossRef]
- Paguirigan JA, G.; Jeong, E.; Kang, K.B.; Hur, J.S.; Kim, W. Investigation of Antimicrobial Compounds Produced by Endolichenic Fungi in Different Culture Media. Plant Pathol. J. 2024, 40, 559. [Google Scholar] [CrossRef]
- Illescas Guevara, J.F.; Candiotti Martinez, K.P.; Vega Gutierrez, P.T.; Araujo Flores, M.; Vega Gutierrez, S.M. Finding Spalting Fungi in the Peruvian Tropical Premontane Cloud Forest on Peruvian Native Wood Species. Forests 2024, 15, 2078. [Google Scholar] [CrossRef]
- Skaltsas, D.N.; Badotti, F.; Vaz, A.B.M.; Silva, F.F.D.; Gazis, R.; Wurdack, K.; Castlebury, L.; Góes-Neto, A.; Chaverri, P. Exploration of stem endophytic communities revealed developmental stage as one of the drivers of fungal endophytic community assemblages in two Amazonian hardwood genera. Sci. Rep. 2019, 9, 12685. [Google Scholar] [CrossRef]
- Suetrong, S.; Preedanon, S.; Kobmoo, N.; Srihom, C.; Somrithipol, S.; Saengkaewsuk, S.; Srikitikulchai, P.; Klaysuban, A.; Nuankaew, S.; Chuaseeharonnachai, C.; et al. Unravelling the hidden diversity of cave mycobiota in Thailand’s Satun Geopark. Sci. Rep. 2023, 13, 19162. [Google Scholar] [CrossRef]
- Li, Y.; Chen, H.; Ma, L.; An, Y.; Wang, H.; Wu, W. Laboratory screening of control agents against isolated fungal pathogens causing postharvest diseases of pitaya in Guizhou, China. Front. Chem. 2022, 10, 942185. [Google Scholar] [CrossRef] [PubMed]
- Tripathi, M.; Joshi, Y.; Gupta, R.C. Assessment of endolichenic fungal diversity in some forests of Kumaun Himalaya. Curr. Sci. 2014, 107, 745–748. [Google Scholar]
- Tripathi, M.; Joshi, Y. Endolichenic Fungi: A Case Study from Uttarakhand. In Endolichenic Fungi: Present and Future Trends; Springer: Singapore, 2019; pp. 119–145. [Google Scholar]
- Devi, D.; Gogoi, R.; Yasmin, F.; Tayung, K. Antimicrobial activity of endolichenic fungi isolated from Cryptothecia sp. against some human test pathogens. Res. J. Pharm. Technol. 2022, 15, 2193–2197. [Google Scholar] [CrossRef]
- Cañón, E.R.P.; de Albuquerque, M.P.; Alves, R.P.; Pereira, A.B.; Victoria, F.D.C. Morphological and molecular characterization of three endolichenic isolates of Xylaria (Xylariaceae), from Cladonia curta Ahti & Marcelli (Cladoniaceae). Plants 2019, 8, 399. [Google Scholar] [CrossRef]
- Wangsawat, N.; Ju, Y.M.; Phosri, C.; Whalley, A.J.; Suwannasai, N. Twelve new taxa of Xylaria associated with termite nests and soil from northeast Thailand. Biology 2021, 10, 575. [Google Scholar] [CrossRef] [PubMed]
- Suryanarayanan, T.S.; Thirunavukkarasu, N. Endolichenic fungi: The lesser-known fungal associates of lichens. Mycology 2017, 8, 189–196. [Google Scholar] [CrossRef]
- Grube, M.; Köberl, M.; Lackner, S.; Berg, C.; Berg, G. Host–parasite interaction and microbiome response: Effects of fungal infections on the bacterial community of the Alpine lichen Solorina crocea. FEMS Microbiol. Ecol. 2012, 82, 472–481. [Google Scholar] [CrossRef] [PubMed]
- Lim, F.Y.; Sanchez, J.F.; Wang, C.C.C.; Keller, N.P. Toward awakening cryptic secondary metabolite gene clusters in filamentous fungi. Methods Enzymol. 2012, 517, 303–324. [Google Scholar]
- Suryanarayanan, T.S.; Govindarajulu, M.B.; Rajamani, T.; Tripathi, M.; Joshi, Y. Endolichenic fungi in lichens of Champawat district, Uttarakhand, northern India. Mycol. Prog. 2017, 16, 205–211. [Google Scholar] [CrossRef]
- Kellogg, J.J.; Raja, H.A. Endolichenic fungi: A new source of rich bioactive secondary metabolites on the horizon. Phytochem. Rev. 2017, 16, 271–293. [Google Scholar] [CrossRef]
- Goga, M.; Elečko, J.; Marcinčinová, M.; Ručová, D.; Bačkorová, M.; Bačkor, M. Lichen Metabolites: An Overview of Some Secondary Metabolites and Their Biological Potential. In Co-Evolution of Secondary Metabolites; Merillon, F., Ramawat, K., Eds.; Springer: Berlin/Heidelberg, Germany, 2020; pp. 175–209. [Google Scholar]
- Poulsen-Silva, E.; Gordillo-Fuenzalida, F.; Atala, C.; Moreno, A.A.; Otero, M.C. Bioactive lichen secondary metabolites and their presence in species from Chile. Metabolites 2023, 13, 805. [Google Scholar] [CrossRef]
- Muggia, L.; Fleischhacker, A.; Kopun, T.; Grube, M. Extremotolerant fungi from alpine rock lichens and their phylogenetic relationships. Fungal Divers. 2016, 76, 119–142. [Google Scholar] [CrossRef]
- Cernava, T.; Müller, H.; Aschenbrenner, I.A.; Grube, M.; Berg, G. Analyzing the antagonistic potential of the lichen microbiome against pathogens by bridging metagenomic with culture studies. Front. Microbiol. 2015, 6, 620. [Google Scholar] [CrossRef]
- Oksanen, I. Ecological and biotechnological aspects of lichens. Appl. Microbiol. Biotechnol. 2006, 73, 723–734. [Google Scholar] [CrossRef]
- Lawrey, J.D.; Lücking, R.; Sipman, H.J.M.; Chaves, J.L.; Redhead, S.A.; Bungartz, F.; Sikaroodi, M.; Gillevet, P.M. High concentration of basidiolichens in a single family of agaricoid mushrooms (Basidiomycota: Agaricales: Hygrophoraceae). Mycol. Res. 2009, 113, 1154–1171. [Google Scholar] [CrossRef] [PubMed]
- Boustie, J.; Tomasi, S.; Grube, M. Bioactive lichen metabolites: Alpine habitats as an untapped source. Phytochem. Rev. 2011, 10, 287–307. [Google Scholar] [CrossRef]
- Logesh, A.R.; Thillaimaharani, K.A.; Sharmila, K.; Kalaiselvam, M.; Raffi, S.M. Production of chitosan from endolichenic fungi isolated from mangrove environment and its antagonistic activity. Asian Pac. J. Trop. Biomed. 2012, 2, 140–143. [Google Scholar] [CrossRef]
- Furmanek, Ł.; Czarnota, P.; Seaward, M.R. A review of the potential of lichen substances as antifungal agents: The effects of extracts and lichen secondary metabolites on Fusarium fungi. Arch. Microbiol. 2022, 204, 523. [Google Scholar] [CrossRef] [PubMed]
- Lyssaios, F.A.; González-Coloma, A.; Andrés, M.F.; Díaz, C.E. Biopesticide Compounds from an Endolichenic Fungus Xylaria sp. Isolated from the Lichen Hypogymnia tubulosa. Molecules 2025, 30, 470. [Google Scholar] [CrossRef]
- Peters, L.P.; Prado, L.S.; Silva, F.I.; Souza, F.S.; Carvalho, C.M. Selection of endophytes as antagonists of Colletotrichum gloeosporioides in açaí palm. Biological Control 2020, 150, 104350. [Google Scholar] [CrossRef]
- Hamzah, T.N.T.; Lee, S.Y.; Hidayat, A.; Terhem, R.; Faridah-Hanum, I.; Mohamed, R. Diversity and characterization of endophytic fungi isolated from the tropical mangrove species, Rhizophora mucronata, and identification of potential antagonists against the soil-borne fungus, Fusarium solani. Front. Microbiol. 2018, 9, 1707. [Google Scholar] [CrossRef]

| Isolate Codes | C. gloeosporioides | C. cladosporioides | F. oxysporum | |||
|---|---|---|---|---|---|---|
| Percent Inhibition (I%) ± SD | Type of Interaction | Percent Inhibition (I%) ± SD | Type of Interaction | Percent Inhibition (I%) ± SD | Type of Interaction | |
| LS 1A.1 | 36.50 ± 4.88 | E | 22.96 ± 8.88 | E | 47.68 ± 5.66 | D |
| LS1A.3.2 | 37.35 ± 8.68 | E | 28.11 ± 13.23 | E | 34.21 ± 5.16 | E |
| LS1A.4 | 50.94 ± 2.74 | B | 35.19 ± 3.55 | D | 49.62 ± 4.62 | D |
| LS1B.1 | 38.29 ± 3.60 | D | 20.39 ± 7.24 | D | 55.91 ± 2.86 | D |
| LS1B.3 | 33.42 ± 5.53 | D | 16.31 ± 4.02 | D | 46.51 ± 3.78 | D |
| LS1B.4 | 38.03 ± 4.49 | D | 22.96 ± 7.06 | D | 49.76 ± 8.64 | D |
| LS1C.1 | 35.38 ± 3.59 | D | 30.90 ± 3.18 | D | 50.17 ± 1.57 | D |
| LS1C.5 | 38.80 ± 1.46 | D | 23.61 ± 4.83 | D | 55.15 ± 5.60 | D |
| LS1D.2 | 50.85 ± 5.85 | D | 34.76 ± 2.90 | D | 45.20 ± 10.56 | D |
| LS1D.3 | 44.02 ± 4.83 | D | 35.84 ± 4.38 | D | 44.51 ± 2.40 | D |
| LS1D.3.2 | 50.09 ± 1.04 | D | 34.76 ± 6.76 | D | 55.77 ± 0.96 | D |
| LS2A.1 | 32.39 ± 2.57 | C | 18.03 ± 10.95 | E | 52.32 ± 5.52 | D |
| LS2A.2 | 41.71 ± 6.07 | D | 47.21 ± 1.70 | D | 51.21 ± 1.53 | D |
| LS2A.4 | 43.42 ± 0.90 | D | 21.89 ± 14.02 | D | 55.70 ± 4.04 | D |
| LS2A.5 | 55.47 ± 3.68 | D | 42.06 ± 3.22 | D | 60.75 ± 5.28 | B |
| LS2B.1 | 51.45 ± 7.44 | D | 21.46 ± 6.14 | D | 61.44 ± 3.87 | D |
| LS2B.3 | 57.78 ± 2.57 | D | 42.06 ± 9.91 | D | 55.70 ± 6.74 | D |
| LS2C.3.2 | 43.85 ± 3.78 | D | 39.70 ± 8.74 | D | 58.47 ± 4.61 | D |
| LSD2.4 | 36.50 ± 5.18 | E | 23.82 ± 10.19 | D | 56.81 ± 6.07 | B |
| LSD2.5 | 40.43 ± 5.97 | D | 15.67 ± 8.94 | D | 59.30 ± 0.78 | D |
| Isolate Codes | C. gloeosporioides | C. cladosporioides | F. oxysporum | |||
|---|---|---|---|---|---|---|
| Percent Inhibition (I%) ± SD | Type of Interaction | Percent Inhibition (I%) ± SD | Type of Interaction | Percent Inhibition (I%) ± SD | Type of Interaction | |
| BG1A.5 | 23.01 ± 2.11 | E | 43.79 ± 3.01 | E | 39.00 ± 2.11 | D |
| BG1B.1.1. A | 25.61 ± 4.68 | E | 38.32 ± 7.63 | E | 27.66 ± 1.28 | D |
| BG1B.1.1. B | 30.73 ± 9.85 | B | 36.76 ± 1.57 | D | 28.45 ± 3.71 | D |
| BG1B.1.2 | 45.56 ± 10.53 | E | 36.08 ± 2.36 | C | 33.14 ± 1.83 | E |
| BG1B.2.2 | 39.15 ± 1.54 | B | 38.47 ± 1.57 | D | 34.90 ± 2.46 | D |
| DBG1B.3.2 | 18.80 ± 1.84 | E | 29.05 ± 0.51 | E | 25.32 ± 1.06 | D |
| BG1B.4.1 | 42.36 ± 7.30 | D | 36.08 ± 3.35 | E | 40.08 ± 10.08 | D |
| BG1C.5.1 | 41.55 ± 1.20 | E | 26.99 ± 5.28 | E | 17.01 ± 0.83 | D |
| BG1D.1 | 38.65 ± 0.17 | E | 24.59 ± 1.36 | E | 33.82 ± 4.69 | D |
| BG1D.5 | 45.56 ± 3.84 | D | 34.36 ± 1.07 | E | 30.50 ± 0.21 | E |
| BG2B.4 | 30.73 ± 4.26 | E | 23.39 ± 5.20 | E | 18.18 ± 0.21 | D |
| BG2C.3 | 26.62 ± 1.84 | E | 36.59 ± 6.20 | E | 26.54 ± 2.07 | D |
| BG3A.1.1 | 38.95 ± 0.76 | E | 42.25 ± 0.89 | E | 30.65 ± 0.83 | D |
| BG3A.5 | 22.61 ± 4.52 | E | 29.73 ± 1.57 | E | 13.20 ± 13.38 | E |
| BG3C.4 | 43.66 ± 2.08 | D | 53.73 ± 1.19 | D | 27.27 ± 3.01 | D |
| BG4B.5.1 | 24.61 ± 5.09 | D | 36.42 ± 4.73 | E | 33.53 ± 9.37 | D |
| BG4C.1 | 41.05 ± 11.84 | E | 34.70 ± 4.31 | E | 16.03 ± 4.99 | E |
| BG5A.4.2 | 32.73 ± 3.59 | E | 32.39 ± 1.65 | E | 28.74 ± 3.00 | D |
| BG5D.2 | 31.23 ± 5.04 | D | 38.99 ± 5.45 | D | 32.75 ± 3.98 | D |
| BG5D.4 | 42.76 ± 1.88 | E | 46.36 ± 0.79 | D | 43.30 ± 0.29 | D |
Disclaimer/Publisher’s Note: The statements, opinions and data contained in all publications are solely those of the individual author(s) and contributor(s) and not of MDPI and/or the editor(s). MDPI and/or the editor(s) disclaim responsibility for any injury to people or property resulting from any ideas, methods, instructions or products referred to in the content. |
© 2025 by the authors. Licensee MDPI, Basel, Switzerland. This article is an open access article distributed under the terms and conditions of the Creative Commons Attribution (CC BY) license (https://creativecommons.org/licenses/by/4.0/).
Share and Cite
Jamilano-Llames, L.C.; dela Cruz, T.E.E. Comparative Antagonistic Activities of Endolichenic Fungi Isolated from the Fruticose Lichens Ramalina and Usnea. J. Fungi 2025, 11, 302. https://doi.org/10.3390/jof11040302
Jamilano-Llames LC, dela Cruz TEE. Comparative Antagonistic Activities of Endolichenic Fungi Isolated from the Fruticose Lichens Ramalina and Usnea. Journal of Fungi. 2025; 11(4):302. https://doi.org/10.3390/jof11040302
Chicago/Turabian StyleJamilano-Llames, Lloyd Christian, and Thomas Edison E. dela Cruz. 2025. "Comparative Antagonistic Activities of Endolichenic Fungi Isolated from the Fruticose Lichens Ramalina and Usnea" Journal of Fungi 11, no. 4: 302. https://doi.org/10.3390/jof11040302
APA StyleJamilano-Llames, L. C., & dela Cruz, T. E. E. (2025). Comparative Antagonistic Activities of Endolichenic Fungi Isolated from the Fruticose Lichens Ramalina and Usnea. Journal of Fungi, 11(4), 302. https://doi.org/10.3390/jof11040302







